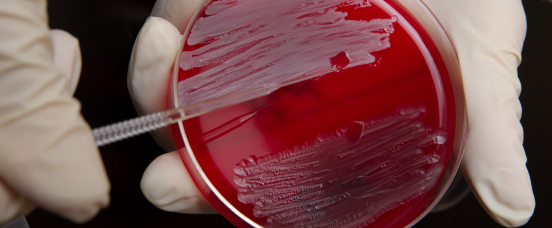

The David J. Sencer CDC Museum is temporarily closed.
Continue to check our website for further updates on when we will reopen. When the museum reopens, all visitors will need to make reservations at least a week in advance. Walk-in visits are no longer permitted.
CDC Timeline 1990s
1990s

1999
- CDC launches National Pharmaceutical Stockpile (now the Strategic National Stockpile), a stockpile of drugs, vaccines, and other medical products and supplies, to provide for the emergency health security of the United States and its territories
- CDC establishes CDC’s Laboratory Response Network, an integrated national and international network of laboratories that are fully equipped to respond quickly to acts of chemical or biological threats, emerging infectious diseases, and other public health threats and emergencies
- CDC responds to the first case of West Nile virus identified in New York City
1998
- For the first time since 1981, AIDS is diagnosed in more African-American and Hispanic men than in white men
- The Fetal Alcohol Syndrome Surveillance Network is created in October and develops a multisource surveillance methodology to determine the prevalence of FAS within certain regions of the United States
- MMWR publishes the first Surgeon General’s report focusing on tobacco use among ethnic and racial minorities
- Enriched Cereal grains will now be fortified with folic acid through a federal mandate to reduce neural tube defects.
- The Global Polio Eradication Initiative launches: a public-private partnership led by national governments and spearheaded by the World Health Organization (WHO), Rotary International, the Centers for Disease Control (CDC), and the United Nations Children’s Fund (UNICEF) with the Gates Foundation joining in 2000

1997
- CDC participates in the nationally-televised White House event of the Presidential Apology for the Tuskegee Study
- CDC convenes a group of organizations dedicated to advocacy and education about folic acid-preventable birth defects. This group becomes the National Council on Folic Acid (NCFA)
- Fenfluramine (fen-phen) diet pill deaths and heart valve damage identified

1996
- CDC establishes the National Occupational Research Agenda (NORA)
- NIOSH issues findings and recommendations for preventing workplace homicides and assaults
- CDC finds measurable levels of serum cotinine, a biomarker of tobacco smoke exposure, in the blood of 88 percent of American nonsmokers
- PulseNet, a national network of laboratories, launches to help detect and define outbreaks using the DNA of the foodborne bacteria making people sick
- Prevention Effectiveness Program and The Guide to Community Preventive Services (The Community Guide) initiated
- As part of the celebration of its 50th anniversary, CDC opens the Global Health Odyssey, a museum designed to educate the public about CDC and public health

1995
- CDC epidemiologists investigate an outbreak of deadly Ebola virus in Zaire
- CDC recommends offering HIV testing to all pregnant women, and AZT therapy for HIV-infected pregnant women to reduce transmission of the virus to their babies
- Emerging Infections Programs (EIP) are established in response to CDC’s 1994 strategy, Addressing Emerging Infectious Disease Threats: A Prevention Strategy for the United States
1994
- Polio elimination is certified in the Americas
- Vaccines for Children Program established

1993
- MMWR reports on an outbreak of a mysterious illness in the southwestern United States, later recognized as Hantavirus infection. The deadly virus is transmitted by infected rodents through urine, droppings, and saliva. CDC responds by developing prevention and information materials for the disease
- CDC establishes the Fetal Alcohol Syndrome Unit in the Division of Birth Defects and Developmental Disabilities at the National Center for Environmental Health
- CDC responds to an H5N1 avian flu outbreak spread to humans
1992
- The agency is renamed Centers for Disease Control and Prevention (CDC) to reflect a broader role and vision. The agency is asked by Congress to continue using the initials “CDC”
- The U.S. Public Health Service recommends that all women who could become pregnant get 400 micrograms (0.4 mg) of folic acid each day to prevent neural tube defects.
- National Center for Injury Prevention and Control (NCIPC) is established

1991
- CDC establishes the Division of Oral Health to expand efforts to prevent oral disease and conditions
- CDC reports a sharp increase in cases of tuberculosis in the United States, linked to HIV infection and AIDS
- CDC begins development of a national strategic plan for early detection and control of breast and cervical cancers among all American women
- CDC recommends that women who had a pregnancy affected by a neural tube defect consume 4000 micrograms (4 mg) folic acid before planning to become pregnant again.2
1990
- CDC reports on the viral agents of gastroenteritis, which causes diarrhea. Before 1990, severe diarrhea was a serious public health threat cause five to ten million deaths worldwide
- CDC develops guidelines for Telecommunications Systems for Surveillance, providing a systematic framework for public health surveillance data reported to CDC
- CDC reports possible transmission of HIV to a patient during invasive dental procedures
- CDC conducts the first national Youth Risk Behavior Survey to measure the prevalence of priority risk behaviors among adolescents
- CDC reports a large outbreak of multidrug-resistant tuberculosis. This outbreak creates significant public health and economic burdens across Texas, California, and Pennsylvania
- CDC and the Pan American Health Organization (PAHO) develop the Safe Water System (SWS), protecting communities from contaminated water by promoting behavior change and providing affordable and sustainable solutions